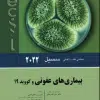
کتاب تنها کتاب تفسیر رادیوگرافی قفسه سینه که نیاز دارید

کتاب تنها کتاب تفسیر رادیوگرافی قفسه سینه که نیاز دارید
200.000 تومان قیمت اصلی: 200.000 تومان بود.164.000 تومانقیمت فعلی: 164.000 تومان.
دسته: اندیشه, کتاب های رادیولوژی و فیزیک
نویسنده:
کریستوفر کلارک
مترجمان:
دکتر محمد مهدی غیرتیان , دکتر آرس تبرائی

دیدگاهها
هیچ دیدگاهی برای این محصول نوشته نشده است.